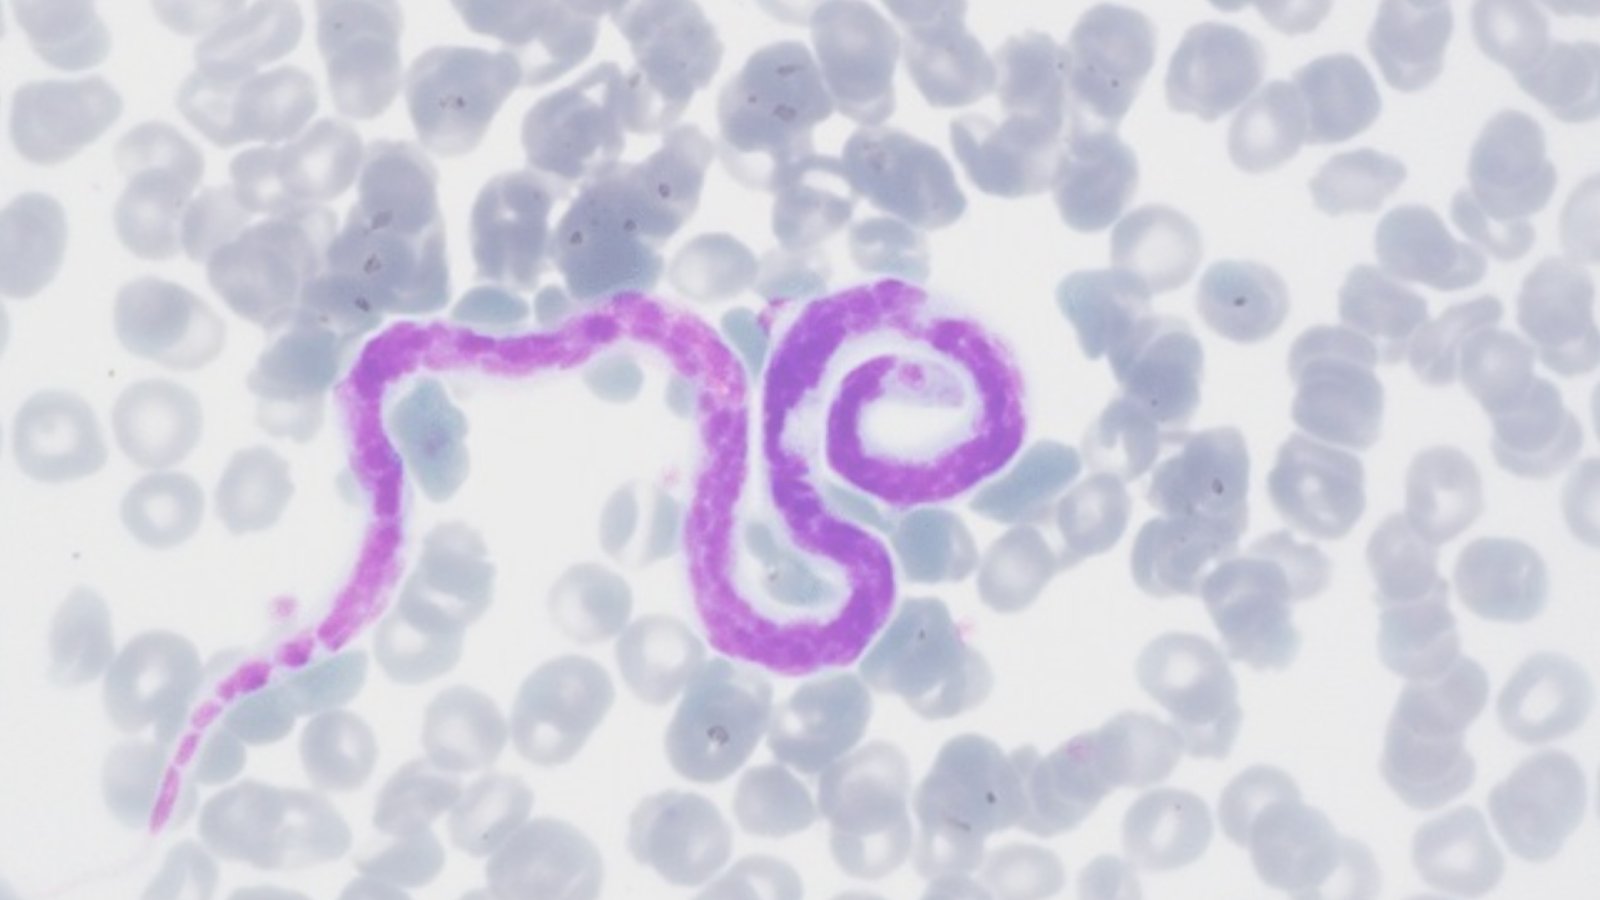
Figure 1. Microscope image of Dirofilaria immitis

Heartworm disease may not seem like an immediate concern to many pet owners, but for veterinarians and animal health professionals, it remains a constant challenge that requires timely and precise diagnosis. Caused by the parasitic roundworm Dirofilaria immitis, canine heartworm (CHW) disease can be life-threatening if not diagnosed in time. The VetFor CHW Detection Kit offers a cutting-edge, molecular solution for reliable detection using real-time PCR (qPCR) technology.
In this blog, we’ll break down the basics of heartworm disease in simple terms, explain why early and precise diagnostics matter, and highlight why the VetFor CHW Detection Kit is the smart choice for veterinary professionals.
What is Canine Heartworm Disease?
Canine heartworm disease is caused by the parasite Dirofilaria immitis. These thread-like worms are transmitted through the bite of an infected mosquito. Once inside the host’s bloodstream, the larvae mature into adult worms and settle in the heart, lungs, and surrounding blood vessels. Over time, this can lead to severe lung disease, heart failure, and damage to other organs in both dogs and cats.
What makes heartworm especially dangerous is its silent nature. In the early stages, there are often no noticeable symptoms. As the disease progresses, pets may develop coughing, fatigue, weight loss, and in severe cases, sudden death.
Unlike some infections that the immune system can fight off, heartworm persists and worsens over time. When adult worms settle in the heart or pulmonary arteries, treating the infection becomes more complicated and expensive, and sadly, the harm caused to the animal’s body may be permanent.
The Importance of Timely and Accurate Diagnosis
Traditional diagnostic methods such as antigen tests or microscopic detection of microfilariae (larval worms) in the blood have limitations. Antigen tests, for example, can fail to detect low-level infections, especially in cats or in early stages when the worms haven’t matured. Microscopy is time-consuming and can easily miss early or light infections.
That’s why molecular diagnostics, like real-time PCR (qPCR), are becoming the gold standard. PCR identifies the parasite’s DNA directly, even before the animal’s immune system reacts or any symptoms appear. This enables early detection, allowing veterinarians to begin treatment sooner and reduce the risk of serious complications. Moreover, early diagnosis can also help in epidemiological tracking, allowing communities and clinics to monitor disease spread and take preventive action.

Introducing VetFor CHW Detection Kit: Precision Diagnostics for Animal Health
The VetFor CHW Detection Kit is a qPCR-based veterinary diagnostic tool developed specifically for the detection of Dirofilaria immitis in dogs and cats. Designed for in vitro diagnostic use in animal health laboratories, the kit offers a fast, sensitive, and specific way to detect heartworm DNA directly from whole blood samples.
Key Advantages
- • High Sensitivity and Specificity
Detects as low as 100 copies/ml of D. immitis DNA. Avoids cross-reactivity with similar pathogens like Brucella, Anaplasma, or Salmonella. - • Rapid and Reliable
Results in just a few hours with minimal hands-on time. Perfect for veterinary clinics and research labs needing rapid turnaround. - • qPCR-Based Detection
Uses TaqMan probe-based real-time PCR for maximum accuracy. Amplifies target DNA and measures fluorescent signals for precise quantification. - • Optimized for Multiple PCR Platforms
Compatible with leading thermal cyclers including Thermo Fisher QuantStudio, Bio-Rad CFX96, Roche LightCycler, and ChainPro NGX16-4F. - • Simple Workflow
Lyophilized reagents for room temperature storage and easier handling in various settings.
How to Use the VetFor CHW Detection Kit
Using the kit is straightforward for any lab experienced in molecular diagnostics. The workflow includes:
🧪 Sample Preparation
- • Collect whole blood from the pet (dogs or cats).
- • Store short-term at +4°C or long-term at -20°C.
🧬 Nucleic Acid Extraction
- Add 200μL blood to the LB well of the extraction card.
- Insert magnetic rod and initiate automatic extraction using the MagPro MGX2.
- Extracted nucleic acid is ready for PCR immediately.
🔬 qPCR Amplification
- Transfer 20μL of extracted nucleic acid into the lyophilized PCR reaction tube.
- Mix gently, ensuring the powder dissolves fully.
- Place into the PCR instrument and run the thermal profile:
- • 95°C for 2 min (initial denaturation)
- • 40 cycles of 95°C for 5 sec, 60°C for 10 sec (data collection at FAM channel)
📈 Interpreting the Results
- • Positive: Ct value <38 with a clear S-curve amplification.
- • Negative: No amplification or Ct ≥38.

Why Choose VetFor for Heartworm Detection?
In a field where every minute and every accurate diagnosis counts, VetFor provides the edge.
- • Veterinarian-Centric Design
Developed specifically for canine and feline samples, with practical considerations for real-world use. - • Minimized Storage Hassles
Reagents stable at room temperature, reducing the burden of cold chain logistics. - • Supports Preventive Care
Enables early-stage screening, even in asymptomatic animals. It is ideal for shelters, breeders, and clinics. - • Excellent Reproducibility
Coefficient of variation (CV) for Ct values across 10 replicates <5%, ensuring dependable performance.
Conclusion
As heartworm disease continues to pose a threat to pets worldwide, embracing modern diagnostic tools like qPCR is essential. The VetFor CHW Detection Kit empowers veterinary professionals with the precision and confidence needed for accurate diagnosis and timely intervention.
Safeguarding animal health starts with awareness and is strengthened through the power of science. VetFor transforms that science into practical, precise, and reliable diagnostic solutions.
References:
- • American Heartworm Society. (2024). Heartworm Basics. Retrieved from: https://www.heartwormsociety.org
- • Bowman, D.D. (2014). Georgis’ Parasitology for Veterinarians. Elsevier Health Sciences.
- • McCall, J.W., et al. (2017). “Heartworm Disease in Dogs and Cats.” Veterinary Clinics of North America.